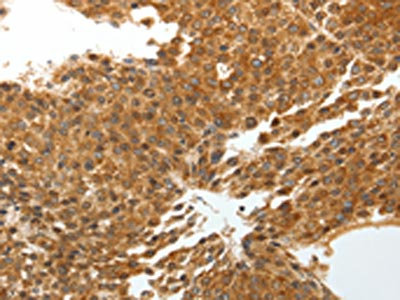

TNXB Antibody
-
中文名稱:TNXB兔多克隆抗體
-
貨號:CSB-PA976408
-
規(guī)格:¥1100
-
圖片:
-
The image on the left is immunohistochemistry of paraffin-embedded Human brain tissue using CSB-PA976408(TNXB Antibody) at dilution 1/40, on the right is treated with synthetic peptide. (Original magnification: ×200)
-
The image on the left is immunohistochemistry of paraffin-embedded Human liver cancer tissue using CSB-PA976408(TNXB Antibody) at dilution 1/40, on the right is treated with synthetic peptide. (Original magnification: ×200)
-
-
其他:
產(chǎn)品詳情
-
Uniprot No.:
-
基因名:
-
別名:EDS3 antibody; Ehlers Danlos like syndrome antibody; Growth inhibiting protein 45 antibody; Hexabrachion like protein antibody; Hexabrachion-like protein antibody; HXBL antibody; NXB2 antibody; Tenascin X antibody; Tenascin X precursor antibody; Tenascin XB antibody; Tenascin XB1 antibody; Tenascin XB2 antibody; Tenascin-X antibody; TENX antibody; TENX_HUMAN antibody; TN X antibody; TN-X antibody; TNX antibody; TNXB antibody; TNXB1 antibody; TNXB2 antibody; TNXBS antibody; VUR8 antibody; XB antibody; XBS antibody
-
宿主:Rabbit
-
反應(yīng)種屬:Human
-
免疫原:Synthetic peptide of Human TNXB
-
免疫原種屬:Homo sapiens (Human)
-
標(biāo)記方式:Non-conjugated
-
抗體亞型:IgG
-
純化方式:Antigen affinity purification
-
濃度:It differs from different batches. Please contact us to confirm it.
-
保存緩沖液:-20°C, pH7.4 PBS, 0.05% NaN3, 40% Glycerol
-
產(chǎn)品提供形式:Liquid
-
應(yīng)用范圍:ELISA,IHC
-
推薦稀釋比:
Application Recommended Dilution ELISA 1:3000-1:10000 IHC 1:50-1:200 -
Protocols:
-
儲存條件:Upon receipt, store at -20°C or -80°C. Avoid repeated freeze.
-
貨期:Basically, we can dispatch the products out in 1-3 working days after receiving your orders. Delivery time maybe differs from different purchasing way or location, please kindly consult your local distributors for specific delivery time.
-
用途:For Research Use Only. Not for use in diagnostic or therapeutic procedures.
相關(guān)產(chǎn)品
靶點(diǎn)詳情
-
功能:Appears to mediate interactions between cells and the extracellular matrix. Substrate-adhesion molecule that appears to inhibit cell migration. Accelerates collagen fibril formation. May play a role in supporting the growth of epithelial tumors.
-
基因功能參考文獻(xiàn):
- mRNA for tenascin-X gene values was higher in ventricular septal defects. PMID: 29470764
- Hypermethylated sites at TNXB are associagted with response to starvation in anorexia nervosa. PMID: 27367046
- Study describes a biallelic TNXB variants in patients with congenital adrenal hyperplasia due to CYP21A2 deletions resulting in a classical Ehlers-Danlos syndrome phenotype with skin hyperextensibility, widened atrophic scars and joint hypermobility. PMID: 27297501
- patients with the TNX-deficient type EDS typically have generalized joint hypermobility, skin hyperextensibility and easy bruising. In contrast to the classical type, the inheritance pattern is autosomal recessive and atrophic scarring is absent. Molecular analysis of TNXB in a diagnostic setting is challenging. PMID: 27582382
- the identification of a rare missense variant in TNXB in combination with a positive family history of VUR and joint hypermobility may represent a non-invasive method to diagnose PVUR and warrants further evaluation in other cohorts PMID: 26408188
- We then quantified the tenascin-X level in serum of patients and identified tenascin-X as potent marker for ovarian cancer, showing that secretomic analysis is suitable for the identification of protein biomarkers when combined with protein immunoassay. PMID: 26090390
- It plays regulatory roles in collagen functions such as fibril organization and fibrillogenesis in calcific aortic valves. PMID: 25926574
- these results suggest that mutations in TNXB can cause hereditary primary vesicoureteral reflux . PMID: 23620400
- Noticeable decreased expression of tenascin-X in calcific aortic valves. PMID: 22827484
- Tenascin-X haploinsufficiency was associated with Ehlers-Danlos syndrome in patients with congenital adrenal hyperplasia PMID: 23284009
- no difference in genotype frequency was detected between patients who experienced a re-dislocation after the initial surgery and patients who did not sustain a re-dislocation. PMID: 22991340
- Genome-wide association study of age-related macular degeneration identifies TNXB, FKBPL and NOTCH4 as candidate susceptibility genes. PMID: 22694956
- Combined analysis of tenascin-C expression and the nodule size improved the prediction of malignancy in this patient cohort. PMID: 22588153
- rs204887 itself or a nearby variant is unlikely to play a major role in the development of schizophrenia although a cumulative contribution of rare variants in the TNXB gene cannot be ruled out. PMID: 21317684
- Three point mutations in TNX gene were found to be associated with hypermobility type Ehlers-Danlos syndrome (EDS) . The phenotypic effects of V1195M mutation on 7th fibronectin Type III domain (TNXfn7) with regards to EDS were investigated. PMID: 20853426
- localization and analysis of the principal promoter for human tenascin-X PMID: 12376099
- chromosomal mapping of a de novo unequal crossover causing a deletion of the steroid 21-hydroxylase gene and a non-functional hybrid tenascin-X gene PMID: 12746407
- The transmission disequilibrium test did not show allelic association between these two TNXB single nucleotide polymorphisms and schizophrenia, and the rs1009382-rs204887 haplotypes were not associated with the illness either. PMID: 14729256
- Both elastic fiber abnormalities and reduced collagen content contribute to the observed phenotype in TNX-deficient patients. PMID: 15102077
- different distributions of tenascin-C and -X were found around the epithelium and the endomysium of the mental symphyseal region, and affect the specific formation of the mandible during ossification in the fetus PMID: 15455729
- elastic fiber abnormalities in hypermobility type Ehlers-Danlos syndrome are specific for TNX-haploinsufficient individuals and confirm an important role for TNX in regulating elastic fiber integrity PMID: 15733269
- Tenascin-X expression is markedly decreased in AAA tissue, and AAA is associated with high serum concentrations of tenascin-X. PMID: 16567571
- TNX contributes to matrix stability and is possibly involved in collagen fibril formation. PMID: 17033827
- Association of the TNXB locus or its adjacent region of the NOTCH4 locus with schizophrenia. PMID: 17192952
- TNXB and TNC may be involved in the malignant transformation of plexiform neurofibromas PMID: 17202312
- Multiple species of TNX in blood were identified and characterized. PMID: 17263730
- TNX is unlikely to be involved in matrix deposition in the early phase of wound healing, but it is required in the later phase when remodeling and maturation of the matrix establishes and improves its biomechanical properties. PMID: 17453911
- TNXB(tenascin XB protein) gene is a candidate gene susceptible to Systemic lupus erythematosus in the Japanese population. PMID: 18058064
- This study showed different patterns of expression of tenascin and fibronectin along the process of tumorigenesis and tumor progression in pleomorphic adenoma, a fact that might play a role in invasion properties of these tumors. PMID: 18091320
- Data indicate a complex architecture of the extracellular matrix in the uterosacral ligaments, with marked differences in tenascin and elastin expression between postmenopausal women with or without pelvic organ prolapse. PMID: 18155129
- TNX-deficient women are at risk of obstetric complications. PMID: 18335242
- These results suggest possible involvement of XB-S in the function of Eg5. PMID: 18679583
- Tenascin-X may be a new diagnostic marker of malignant mesothelioma in the differential diagnosis of cancers involving the serosal cavities. PMID: 19738457
顯示更多
收起更多
-
相關(guān)疾病:Ehlers-Danlos syndrome due to tenascin X deficiency (EDSTNXD); Vesicoureteral reflux 8 (VUR8)
-
亞細(xì)胞定位:Secreted, extracellular space, extracellular matrix.
-
蛋白家族:Tenascin family
-
組織特異性:Highly expressed in fetal adrenal, in fetal testis, fetal smooth, striated and cardiac muscle. Isoform XB-short is only expressed in the adrenal gland.
-
數(shù)據(jù)庫鏈接:
Most popular with customers
-
-
YWHAB Recombinant Monoclonal Antibody
Applications: ELISA, WB, IHC, IF, FC
Species Reactivity: Human, Mouse, Rat
-
Phospho-YAP1 (S127) Recombinant Monoclonal Antibody
Applications: ELISA, WB, IHC
Species Reactivity: Human
-
-
-
-
-